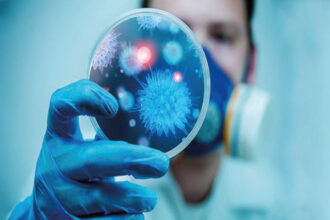

Meslek Seçiminde Dikkat Edeceğiniz Unsurlar!!
Meslek seçimi, hayatınızın büyük bir kısmını etkileyen ve uzun vadeli bir etki…
Civanperçeminin Faydaları? Nasıl Tüketilmeli?
Civanperçemi (Achillea millefolium), tarih boyunca çeşitli kültürlerde kullanılan ve geleneksel tıpta değer…
Uyku Aknesi Nedir? Neden Oluşur?
Uyku aknesi, genellikle yüz, boyun, sırt veya omuzlarda görülen, uyku sırasında cilt…
Panik Atak Anında Alınacak Önlemler Nelerdir?
Panik Atak Anında Alınacak Önlemler: Panik atak anında rahatlamak ve durumu kontrol…
Vitamin Eksikliğinin Sebepleri? Belirtileri Nelerdir?
Vitamin eksikliği, vücutta bir veya birden fazla vitaminin yeterince alınamaması durumunu ifade…
Çayın Faydaları Ve Zararları Nelerdir?
Çayın Faydaları Ve Zararları Nelerdir: Çay, genellikle bitki yaprakları veya diğer bitki…
Kuşburnu’nun Faydaları Nelerdir?
Kuşburnu, küçük ve parlak kırmızı meyveleri olan bir bitki olan gülgiller (Rosaceae)…
Kronik Hastalıkların Belirtileri Nelerdir?
Kronik hastalıklar: Genellikle iyileştirilemeyen veya tamamen ortadan kaldırılamayan hastalıklardır. Bu tür hastalıklar…
Şalgam Suyunun Faydaları Neledir?
Şalgam suyu, şalgam kökü ve suyunun fermente edilerek elde edildiği bir içecektir.…
Bağışıklık Sistemimizi Nasıl Güçlendiririz?
Bağışıklık sistemi, vücudu hastalıklara ve zararlı organizmalara karşı koruyan karmaşık bir savunma…